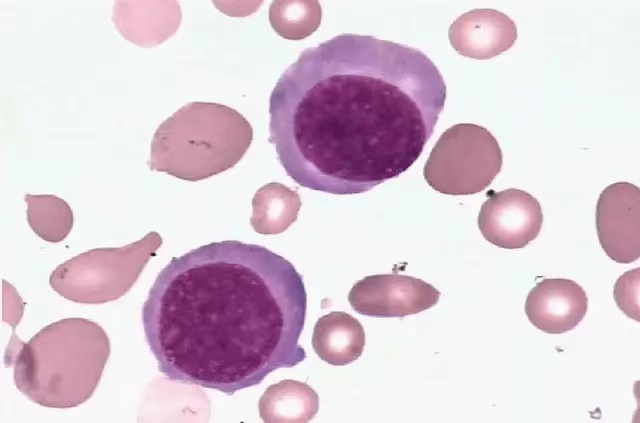

对于贫血患者,血液科医生常规行网织红细胞计数检查。什么是网织红细胞计数?有何意义呢?首先让我来带大家认识一下网织红细胞(RC)。
RC是尚未完全成熟的红细胞,是晚幼红脱核后到完全成熟之间的过渡型细胞。由于胞质内还残存多少不等核糖体、核糖核酸等嗜碱性物质,用煌焦油蓝或新亚加蓝染液进行活体染色,嗜碱物质凝集成颗粒,其颗粒又连缀成线,构成浅蓝或深蓝的网织状结构而得名。


正常情况下,血液中的红细胞均有骨髓产生后,发育成熟后释放入外周血液循环,尚需24-48h合成最后20%的Hb,成为成熟红细胞。网织红细胞较成熟红细胞稍大,是wright染色血涂片中的嗜多色性红细胞。
一、网织红细胞计数:
参考范围:百分率 0.5-1.5%;绝对计数 (24-84)x109/L;
临床意义:网织红细胞反映骨髓红细胞生成能力。主要用于:鉴别红细胞减少疾病、溶血性疾病;检测治疗或造血干细胞移植骨髓造血功能;判断隐性失血的有效指标;监测放疗及化疗对骨髓造血功能的影响。
1.RC增多:表示骨髓红细胞系增生旺盛。主要见于:
(1)溶血性贫血:大量RC因骨髓受到缺氧及大量红细胞破坏产物的刺激而增多并提前进入外周血,使RC明显增多;常在5%以上,严重可达20%以上,40~50%以上;
(2)急性失血:出血停止后RC逐渐恢复正常,临床上应用这一特点来判断出血是否停止;急性失血后5-10天,RC达高峰,2周后恢复正常。
2.RC减少:表示骨髓红系增生减低。主要见于:
(1)再生障碍性贫血AA
(2)溶贫再生障碍危象
(3)急性白血病
(4)某些化学药物引起造血功能减退
二、网织红细胞血红蛋白含量(reticulocyte hemoglobin content,CHr):
参考范围:30.3-35.9pg
临床意义:
1.RC寿命短,仅为1-2天
2.铁缺乏时CHr减低变化较快,可直接反映新生红细胞中Hb的合成水平
3.是诊断铁缺乏的一项早期、灵敏的指标
4.可作为铁缺乏普查,怀疑儿童、孕妇缺铁时筛查、慢性病贫血、透析病人功能性铁缺乏等鉴别诊断的首选指标
5.亦可用于评估铁剂和EPO治疗的效果

文章仅用于公益科普及学术交流,部分资料和图片来源于网络,如有侵权,请联系删除。


